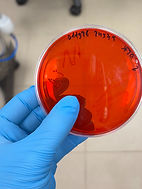
IMG_1233_edited_edited.jpg

Our Research
Fc-engineering of antibodies to reveal mechanisms of innate immune cell activation against enteric pathogens
We know that certain antibodies protect against bacterial pathogens, but we don't yet understand exactly how they work. By engineering modified versions of bacteria-specific monoclonal antibodies with enhanced or reduced abilities to activate immune cells, we'll pinpoint the precise mechanisms antibodies use to restrict infection. This approach will reveal which antibody features are most critical for protection and can be extended to study other pathogens.
Discovering protective antibody features by high throughput antibody profiling of human samples
We're building a cutting-edge platform to uncover how antibodies protect against deadly gut pathogens like Shigella, Cholera, and Klebsiella. By analyzing blood, breast milk, and saliva samples from infected individuals, mothers and babies, and vaccinated people collected all over the world, we'll identify the specific antibody features that actually prevent disease. These discoveries will be crucial for designing better vaccines that work in the real-world settings where they're needed most.
Elucidating the role of gut resident bacteria-specific antibodies in protection against enteric infection and response to vaccination
Vaccines against gut pathogens that work well in wealthy countries often fail in low-resource settings, and we believe differences in gut bacteria may be key to understanding why. We're developing methods to profile antibodies against gut-resident bacteria in breast milk and infant blood, and correlate these with the actual bacteria living in babies' guts. By mapping how these antibodies evolve in early life and influence gut resident bacteria composition, we'll uncover whether gut bacteria-specific antibodies affect vaccine responses, potentially explaining why the same vaccines work differently across different populations.